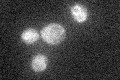
YHL022C
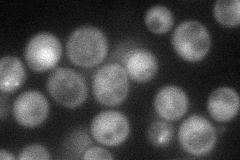
YHL022C
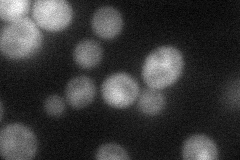
YHL022C
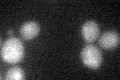
YHL022C

View description
Meiosis-specific protein that initiates meiotic recombination by catalyzing the formation of double-strand breaks in DNA via a transesterification reaction; required for homologous chromosome pairing and synaptonemal complex formation
Localization:
Intensity:
Fold change:
Significance:
-
C’ GFP library in SD
below threshold19.39 -
N' NOP1pr-GFP in SD
cytosol47.6361 -
N' TEF2pr-mCherry in SD
cytosol32.0245 -
N' NATIVEpr-GFP in SD

below threshold19.8478 -
N' TEF2pr-VC and Cyto-VN in SD

#N/A0 -
C’ GFP library in SD+DTT
cytosol15.90.81No -
C’ GFP library in SD+H2O2

cytosol18.250.94No -
C’ GFP library in Starvation Media

cytosol22.821.17No -
C’ GFP library on the background of Pup2-DaMP

below threshold -
C’ GFP library on the background of CCT mutant

below threshold18.89020.9739No
